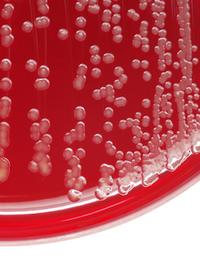

Lutte contre le paludisme : 2 insecticides plutôt qu’un sur les moustiquaires !
Alors que la résistance des anophèles aux pyréthrinoïdes gagne du terrain, de nouvelles moustiquaires imprégnées de 2 insecticides actifs montrent leur efficacité dans le temps pour protéger du paludisme. Si tant est qu’on les utilise… L’utilisation de moustiquaires imprégnées d’insecticides à longue durée d'action (MILD) est la principale méthode de lutte antivectorielle contre le paludisme en Afrique subsaharienne [1].